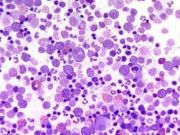

העלאות של Motyk
מתוך ויקירפואה
דף מיוחד זה מציג את כל הקבצים שהועלו.
| תאריך | שם | תמונה ממוזערת | גודל | תיאור | גרסאות |
|---|---|---|---|---|---|
| 05:35, 19 בנובמבר 2021 | AdultPainMed-027.PNG (קובץ) |  |
86 קילו־בייטים | 1 | |
| 05:32, 19 בנובמבר 2021 | AdultPainMed-026.PNG (קובץ) | 12 קילו־בייטים | 1 | ||
| 05:31, 19 בנובמבר 2021 | AdultPainMed-025.PNG (קובץ) |  |
37 קילו־בייטים | 1 | |
| 05:27, 19 בנובמבר 2021 | AdultPainMed-024.PNG (קובץ) |  |
151 קילו־בייטים | 1 | |
| 05:22, 19 בנובמבר 2021 | AdultPainMed-023.PNG (קובץ) |  |
164 קילו־בייטים | 1 | |
| 18:31, 18 בנובמבר 2021 | AdultPainMed-022.PNG (קובץ) | 37 קילו־בייטים | 1 | ||
| 18:30, 18 בנובמבר 2021 | AdultPainMed-021.PNG (קובץ) |  |
185 קילו־בייטים | 1 | |
| 18:28, 18 בנובמבר 2021 | AdultPainMed-020.PNG (קובץ) |  |
152 קילו־בייטים | 1 | |
| 18:24, 18 בנובמבר 2021 | AdultPainMed-019.PNG (קובץ) |  |
160 קילו־בייטים | 1 | |
| 17:31, 18 בנובמבר 2021 | AdultPainMed-018.PNG (קובץ) | 37 קילו־בייטים | 1 | ||
| 17:29, 18 בנובמבר 2021 | AdultPainMed-017.PNG (קובץ) | 81 קילו־בייטים | 1 | ||
| 17:25, 18 בנובמבר 2021 | AdultPainMed-016.PNG (קובץ) |  |
73 קילו־בייטים | 1 | |
| 16:31, 18 בנובמבר 2021 | AdultPainMed-015.PNG (קובץ) | 27 קילו־בייטים | 1 | ||
| 16:31, 18 בנובמבר 2021 | AdultPainMed-014.PNG (קובץ) |  |
112 קילו־בייטים | 1 | |
| 14:48, 18 בנובמבר 2021 | AdultPainMed-013.PNG (קובץ) |  |
47 קילו־בייטים | 1 | |
| 13:12, 18 בנובמבר 2021 | AdultPainMed-012.PNG (קובץ) | 37 קילו־בייטים | 1 | ||
| 08:58, 18 בנובמבר 2021 | AdultPainMed-011.PNG (קובץ) |  |
120 קילו־בייטים | 1 | |
| 08:03, 18 בנובמבר 2021 | AdultPainMed-010.PNG (קובץ) |  |
76 קילו־בייטים | 1 | |
| 07:02, 18 בנובמבר 2021 | AdultPainMed-009.PNG (קובץ) | 38 קילו־בייטים | 1 | ||
| 06:13, 18 בנובמבר 2021 | AdultPainMed-008.PNG (קובץ) |  |
144 קילו־בייטים | 1 | |
| 06:03, 18 בנובמבר 2021 | AdultPainMed-007.PNG (קובץ) |  |
145 קילו־בייטים | 1 | |
| 19:09, 17 בנובמבר 2021 | AdultPainMed-006.PNG (קובץ) | 34 קילו־בייטים | 1 | ||
| 19:00, 17 בנובמבר 2021 | AdultPainMed-005.PNG (קובץ) |  |
95 קילו־בייטים | 1 | |
| 14:45, 17 בנובמבר 2021 | AdultPainMed-004.PNG (קובץ) | 13 קילו־בייטים | 1 | ||
| 14:25, 17 בנובמבר 2021 | AdultPainMed-002.PNG (קובץ) |  |
92 קילו־בייטים | 1 | |
| 12:33, 17 בנובמבר 2021 | AdultPainMed-003.PNG (קובץ) | 28 קילו־בייטים | 1 | ||
| 10:20, 17 בנובמבר 2021 | AdultPainMed-001.PNG (קובץ) |  |
100 קילו־בייטים | 1 | |
| 13:49, 11 בנובמבר 2021 | Klotho2.png (קובץ) |  |
150 קילו־בייטים | 1 | |
| 13:41, 11 בנובמבר 2021 | Klotho1.png (קובץ) |  |
144 קילו־בייטים | 1 | |
| 07:55, 8 בנובמבר 2021 | RID.PNG (קובץ) | 9 קילו־בייטים | 1 | ||
| 18:06, 7 בנובמבר 2021 | דימות2.jpg (קובץ) |  |
19 קילו־בייטים | 1 | |
| 16:09, 7 בנובמבר 2021 | הדמיה.jpg (קובץ) | שגיאה ביצירת תמונה ממוזערת: קובץ בגודל של יותר מ־12.5 מגה־פיקסלים |
765 קילו־בייטים | 1 | |
| 20:16, 25 באוקטובר 2021 | קדמיום 2.jpg (קובץ) |  |
51 קילו־בייטים | 1 | |
| 15:54, 25 באוקטובר 2021 | קדמיום 1.jpg (קובץ) |  |
34 קילו־בייטים | 1 | |
| 14:06, 25 באוקטובר 2021 | ספחת - פסוריאזיס.jpg (קובץ) |  |
910 קילו־בייטים | 1 | |
| 13:45, 25 באוקטובר 2021 | פסוריאזיס - ספחת.jpg (קובץ) |  |
1.45 מגה־בייטים | 1 | |
| 06:59, 20 באוקטובר 2021 | F2-isoprostanes.png (קובץ) |  |
128 קילו־בייטים | 1 | |
| 07:35, 3 באוקטובר 2021 | Desmin 2.png (קובץ) |  |
411 קילו־בייטים | 1 | |
| 07:12, 3 באוקטובר 2021 | Desmin 1.png (קובץ) |  |
20 קילו־בייטים | 1 | |
| 06:22, 29 בספטמבר 2021 | Vimentin 1.jpg (קובץ) |  |
74 קילו־בייטים | 1 | |
| 18:08, 19 בספטמבר 2021 | אריתרופויאזה-3.jpg (קובץ) | |
42 קילו־בייטים | 1 | |
| 18:07, 19 בספטמבר 2021 | תרומבוציט -2.jpg (קובץ) |  |
24 קילו־בייטים | 1 | |
| 15:16, 19 בספטמבר 2021 | מגקריוציטים-1.jpg (קובץ) |  |
41 קילו־בייטים | 1 | |
| 12:29, 12 בספטמבר 2021 | Dengue 3.png (קובץ) |  |
197 קילו־בייטים | 1 | |
| 12:24, 12 בספטמבר 2021 | Dengue-2.png (קובץ) |  |
118 קילו־בייטים | 1 | |
| 12:11, 12 בספטמבר 2021 | Dengue-1.png (קובץ) |  |
695 קילו־בייטים | 1 | |
| 04:47, 1 בספטמבר 2021 | Pain-t-44.PNG (קובץ) | 58 קילו־בייטים | 1 | ||
| 20:38, 31 באוגוסט 2021 | Pain-t-16.PNG (קובץ) |  |
121 קילו־בייטים | 1 | |
| 20:33, 31 באוגוסט 2021 | Pain-t-15.PNG (קובץ) |  |
114 קילו־בייטים | 2 | |
| 14:23, 29 באוגוסט 2021 | CGRP2.jpg (קובץ) |  |
132 קילו־בייטים | 1 |


 כניסה
כניסה  עקבו אחרינו בפייסבוק
עקבו אחרינו בפייסבוק